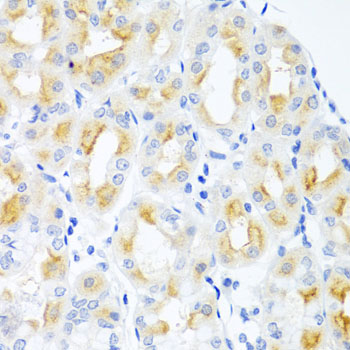
Immunohistochemistry - CGB Polyclonal Antibody

-
Product Name
CGB Polyclonal Antibody
- Documents
-
Description
Polyclonal antibody to CGB
-
Tested applications
WB, IHC
-
Species reactivity
Human
-
Alternative names
CGB3 antibody; CGB antibody; CGB5 antibody; CGB7 antibody; CGB8 antibody; hCGB antibody; choriogonadotropin subunit beta 3 antibody
-
Isotype
Rabbit IgG
-
Preparation
Antigen: Recombinant protein of human CGB
-
Clonality
Polyclonal
-
Formulation
PBS with 0.02% sodium azide, 50% glycerol, pH7.3.
-
Storage instructions
Store at -20℃. Avoid freeze / thaw cycles.
-
Applications
WB 1:500 - 1:2000
IHC 1:50 - 1:200 -
Validations

Western blot - CGB Polyclonal Antibody
Western blot analysis of extracts of various cell lines, using CGB Antibody at 1:500 dilution.Secondary antibody: HRP Goat Anti-Rabbit IgG (H+L) at 1:10000 dilution.Lysates/proteins: 25ug per lane.Blocking buffer: 3% nonfat dry milk in TBST.Detection: ECL Enhanced Kit .Exposure time: 60s.
Immunohistochemistry - CGB Polyclonal Antibody
Immunohistochemistry of paraffin-embedded human stomach using CGB antibody at dilution of 1:100 (40x lens).
-
Background
Beta subunit of the human chorionic gonadotropin (hCG). hCG is a complex glycoprotein composed of two glycosylated subunits alpha and beta which are non-covalently associated. The alpha subunit is identical to those in the pituitary gonadotropin hormones (LH, FSH and TSH). The beta subunits are distinct in each of the hormones and confer receptor and biological specificity. Has an essential role in pregnancy and maternal adaptation. Stimulates the ovaries to synthesize the steroids that are essential for the maintenance of pregnancy.
Related Products / Services
Please note: All products are "FOR RESEARCH USE ONLY AND ARE NOT INTENDED FOR DIAGNOSTIC OR THERAPEUTIC USE"
